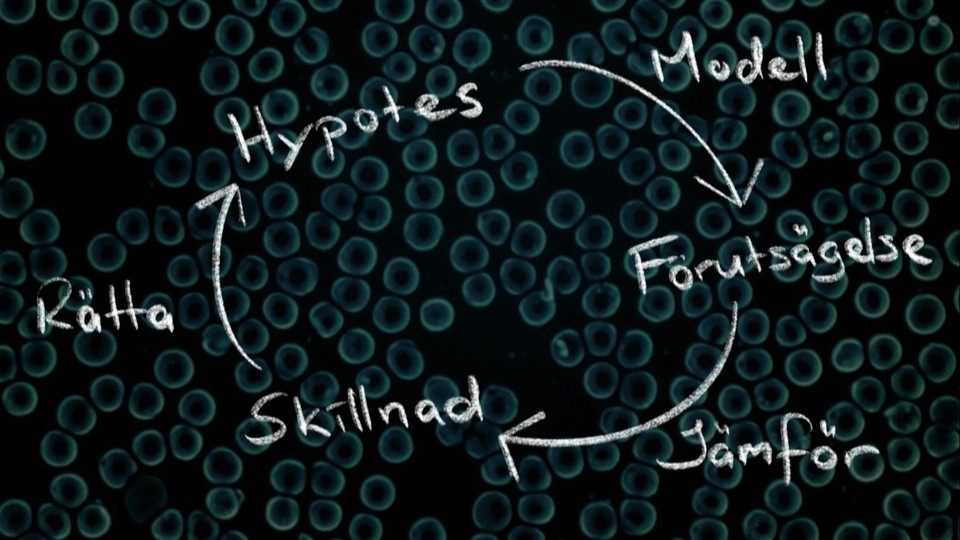
Programbild

Matematik för att räkna celler
Om programmet
Varifrån kom alla de proteiner som fångats upp av ett membran täckt av antikroppar? Frågan är relevant för till exempel framställningen av vaccin, och kan besvaras med hjälp av matematik. Joakim Jaldén, professor i signalbehandling, berättar om sin forskning. Inspelat den 26 november 2019 på Nalen i Stockholm. Arrangör: Vetenskap & Allmänhet.
- Ämnesord:
- Biologi, Celler, Fysiologi, Naturvetenskap, Proteiner
Pedagogiskt syfte
- Utbildningsnivå:
- Högskola
- Ämne:
- Biologi, Kropp och hälsa
Vi har för närvarande inget arbetsmaterial för detta program.
Läs mer om hur vi arbetar med pedagogik och arbetsmaterial